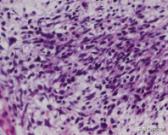
胚胎横纹肌肉瘤是怎么形成的,横纹肌肉瘤转移全身能活多久
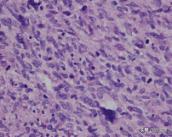
胚胎横纹肌肉瘤是怎么形成的,横纹肌肉瘤转移全身能活多久

本次课程,来自中国骨科菁英会骨肿瘤专业会员、中国医学科学院肿瘤医院的许宋锋医生,向大家分享的课程题目是“你所不知道的横纹肌肉瘤”。
本期嘉宾

许宋锋
中国骨科菁英会骨肿瘤专业会员
中国医学科学院肿瘤医院
你所不知道的横纹肌肉瘤 00:0005:32
学习笔记
01 什么是横纹肌肉瘤?
横纹肌肉瘤(Rhabdomyosarcoma,RMS)是一种具有骨骼肌分化倾向的原始间叶性恶性肿瘤。
大概占所有软组织肉瘤的2-5%,常见于儿童和青少年,少见于成人。美国15岁以下儿童的发病率为4.6/10万,45岁以上的中老年则较为罕见。男性略多,男/女为1.2-1.3。
02 横纹肌肉瘤分型的变化
横纹肌肉肉瘤分型
2020年版的WHO分类将横纹肌肉瘤分为4型:
- 胚胎性
- 腺泡状
- 多形性
- 梭形细胞性横纹肌肉瘤(embryonal, alveolar, pleomorphic, and spindle cell/sclerosing)
梭形细胞性横纹肌肉瘤分型
- 先天性梭形细胞横纹肌肉瘤伴VGLL2/NCOA2/CITED2重排
- MYOD1-突变梭形细胞性/硬化性横纹肌肉瘤
- 骨内梭形细胞性横纹肌肉瘤(伴TFCP2/NCOA2重排)
上述三种亚型的梭形细胞性横纹肌肉瘤,它们的形态、临床行为和潜在的分子改变差异很大。
先天性梭形细胞横纹肌肉瘤伴VGLL2/NCOA2/CITED2重排的患者的预后较好,MYOD1-突变梭形细胞性/硬化性横纹肌肉瘤的患者的临床进展较快,骨内梭形细胞性横纹肌肉瘤 (伴TFCP2/NCOA2重排)显示上皮样细胞呈片状或束状排列的区域。
胚胎性横纹肉瘤分型
- 梭形细胞
- 葡萄状
- 间变性
腺泡状&多形性横纹肌肉瘤
腺泡状横纹肌肉瘤(alveolar rhabdomyosarcoma,ARMS)较常见,约占31%,仅次于胚胎性横纹肌肉瘤。多形性横纹肌肉瘤(pleomorphic rhabdomyosarcoma,PRMS)较少见,占5%以下。
03 好发部位有哪些?
3大好发部位
- 头颈部(44%)
- 躯干(包括泌尿生殖道,41.4%)
- 四肢(14.6%)
具体发生部位及症状
#头颈部
头颈部的最常见于脑膜旁,其次为眼眶,表现为眼眶内上方生长迅速的无痛性肿块,可引起眼球突出、偏位、视力模糊和复视等症状。
#躯干(泌尿生殖道)
泌尿生殖道的主要位于*丸睾**旁,好发于青少年,表现为单侧生长的无痛性肿块,可累及精索和附睾,腹膜后和主动脉旁淋巴结也常受累。
#四肢
四肢的主要位于前臂、手和足。除上述之外,少数横纹肌肉瘤还可发生于胆管、纵膈、心脏、肺、肝、肾、皮肤和骨等处。
04 影像表现有何特点?
横纹肌肉瘤影像学表现缺乏特异性。
MRI检查时,T1WI表现为和软组织等信号或接近等信号,T2WI表现为高信号,如有坏死表现为更高信号区,如有出血,在T1WI、T2WI上均表现为高信号,增强后有强化表现。


男,65岁,左大腿横纹肌肉瘤,侵及左股骨
05 如何确诊?
诊断主要依据组织学表现和免疫组化检查。

胚胎性(葡萄簇状)横纹肌肉瘤,HE ×200,desmin(+),Myogenin(+)



腺泡状横纹肌肉瘤,HE×100,Desmin(+),Myogenin(+)

多形性横纹肌肉瘤,HE×200,Desmin(+),MyoD1(+)
06 如何治疗?
治疗
手术+放疗、化疗等综合治疗。
晚期:局部广泛切除+放疗、化疗等手段。
放疗
- 单纯放疗只适用于不可手术的或拒绝手术治疗,可以使部分肉瘤略有缩小或暂时性控制其发展,只作为姑息治疗的手段;
- 术前放疗一般照射4500cGy,放疗结束后3周左右手术;
- 术后放疗一般于手术后3~4周开始,达到5000cGy。
化疗
VAC方案、加用ADM的VAC、以ADM和DTIC为主的AD方案(ADM+DTIC)和CVAD方案(CTX+VCR+ ADM+DTIC)等,新近则有DDP、VP-16、IFO和Melphalan等。
儿童无转移RMS(中或高风险)的标准化疗方案包括长春新碱、放线菌素D和环磷酰胺(VAC)。
长春新碱、阿霉素、环磷酰胺交替使用异环磷酰胺和依托泊苷 (VAC-IE)对中度风险RMS有效。
目前,没有成人RMS标准化疗方案离开,可以使用长春新碱和放线菌素D(有或无环磷酰胺),长春新碱、阿霉素和环磷酰胺(单独或交替使用异环磷酰胺、依托泊苷),长春新碱、阿霉素和异环磷酰胺。对中枢神经系统或软脑膜受累的患者,放疗无效时,可以考虑大剂量甲氨喋呤。
作者结语
本次菁讲课程,针对较少见的横纹肌肉瘤,从定义、分型变化、流行病学特征,到影像、病理和治疗,进行了提纲携领的阐述,有助于临床医生对该病的更深入认识及临床诊治。